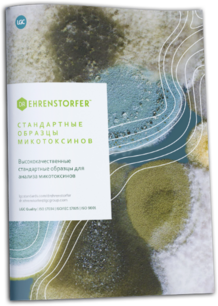

График работы:
Пн-Пт: с 09:00 до 17:00 Сб-Вс: выходной
Пн-Пт: с 09:00 до 17:00 Сб-Вс: выходной
Контакты:
Главная
Доставка
Новости
Контакты

+375 (29) 608-44-53
info@vonka.by
Химические реактивы и стандартные образцы

TCI

Edqm

LGC Dr. Ehrenstorfer

USP

ITW Reagents (PanReac AppliChem)

Honeywell

ABCR

Acros Organics

Alfa Aesar

Avantor

LGC Mikromol

British Pharmacopoeia

Cambridge Isotope Laboratories

Clearsynth

HiMedia Laboratories

Isolab

Larodan

Molcan

PerkinElmer

Pharmaffiliates

Reagecon

Scharlab

Sigma-Aldrich

TLC Pharmaceutical Standards

Thermo Fisher Scientific

Carl Roth

Agilent

TRC

Merck

HPC
У ВАС ОСТАЛИСЬ ВОПРОСЫ?
У ВАС ОСТАЛИСЬ ВОПРОСЫ?
Заполните форму и наш менеджер вас проконсультирует
Заполните форму и наш менеджер вас проконсультирует
Брошюры по реактивам и стандартам:

Реактивы, органические стандарты, хроматографические расходные материалы, лабораторное стекло

Растворители для газовой хроматографии

Растворители
для GM-MS
для GM-MS

Метанол Ultragradient

Реагенты для хроматографии

Стандарты для GC

Стандарты для Атомно-Абсорбционной Спектроскопии (ААС)

Анализ топлива

Волюметрические растворы

Стандарты проводимости

Детергенты

Абсорбенты Chemispill® от Scharlab для ликвидации случайных разливов реагентов в лаборатории

Стандарты проводимости

Стандартные буферные растворы для калибровки pH-метра
Стандартные образцы микотоксинов от LGC Dr. Ehrenstorfer
Брошюры по реактивам Merck:

Анализ на микроэлементы. Реагенты для пробоподготовки, анализа и калибровки

Сertipur - не все стандарты одинаковы

Emsure Emparta - Растворители для химического анализа, высочайшее качество, различные области примен

Extran - Моющие средства. Идеальное решение для очистки лабораторных принадлежностей

Безупречное определение содержания воды. Реагенты Aquastar для титрования по методу Карла-Фишера

Волшебная шкатулка Titripac для волюметрических и буферных растворов

Обзор реагентов для титрования и метода Карла-Фишера

Мера всех веществ. Волюметрические растворы компании Мерк
+375 (29) 608-44-53
info@vonka.by
VONKA
Наши контакты:
График работы:
Пн-Пт с 09:00 до 17:00
Сб-ВС выходной
Сб-ВС выходной
Пн-Пт с 09:00 до 17:00
Сб-ВС выходной
Сб-ВС выходной